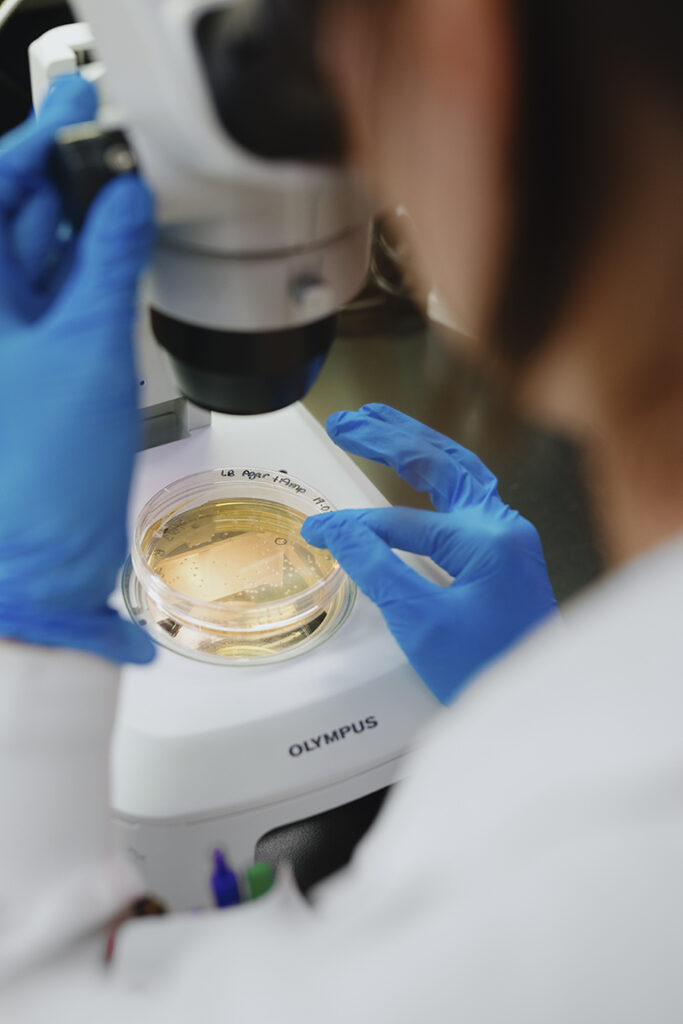
iucpq zoom

Fondation IUCPQ
[email protected] | 418 656-4999
fondation-iucpq.org
« Chaque dollar amassé, chaque projet soutenu participe à la mission de l’IUCPQ », lance-t-il avec conviction. En poste depuis peu, mais fort de ses 25 ans d’expérience en gestion, dont huit dans le secteur de la santé, Francis Morin aborde ce défi avec humilité et passion. « On a ici, à Québec, un joyau qui fait une différence bien au-delà de nos frontières. À l’aube de la cinquantaine, j’ai envie de contribuer directement à une mission qui génère un réel impact et lutte contre les grandes maladies sociétales. »
Rappelons que l’IUCPQ dessert plus de 2,2 millions de personnes et traite certains des cas les plus complexes au pays. Acquisition d’équipements de pointe, mais aussi formation des équipes médicales, développement de nouvelles pratiques et financement de la recherche : grâce à l’appui de la Fondation IUCPQ, des projets d’envergure voient constamment le jour dans les trois axes majeurs que sont la cardiologie, la pneumologie et la santé métabolique.
« Ces domaines touchent directement le quotidien des gens. Les avancées réalisées à l’IUCPQ ont des répercussions concrètes sur les soins, la prévention et la qualité de vie des patients. Mais pour que les idées puissent se matérialiser, la mobilisation de nombreux acteurs est nécessaire. Ainsi, chercheurs, médecins, patients, donateurs et communauté d’affaires doivent unir leurs forces », tient à mentionner le directeur général de la Fondation.
Une initiative pour améliorer le dépistage du cancer du poumon
Cette mobilisation essentielle et chère à Francis Morin prend tout son sens dans des projets tels que SynergiQC, une initiative révolutionnaire destinée à améliorer le dépistage du cancer du poumon, le plus meurtrier dans les pays industrialisés. Dirigé par Drs Philippe Joubert et Yohan Bossé, chercheurs au Centre de recherche de l’IUCPQ, ce projet unique mise sur la puissance de l’intelligence artificielle dans l’objectif de pouvoir mieux cibler les patients à haut risque parmi les 380 000 Québécois concernés.
L’approche est novatrice : combiner le profil génétique, les marqueurs métaboliques et les données d’imagerie médicale afin de créer un modèle prédictif complet. Objectif : identifier rapidement les personnes qui doivent passer des examens plus poussés, réduire les coûts et, surtout, sauver des vies. Pour y parvenir, les chercheurs s’appuient sur des ressources comme la Biobanque de l’IUCPQ, de même que sur les données du projet pilote déjà en cours. Et la Fondation IUCPQ est au cœur de cette avancée, grâce à son soutien financier, qui agit comme un véritable catalyseur pour transformer la science en solutions concrètes.

« La philanthropie est pour moi un moteur de transformation. Elle va bien au-delà de contribuer financièrement. Elle permet de pérenniser des projets porteurs pour notre collectivité. Je crois qu’il faut mobiliser aujourd’hui pour changer demain, car ce que nous bâtissons tous ensemble, c’est un héritage pour les générations futures. »
Francis Morin, directeur général de la Fondation IUCPQ
Une histoire de cœur… et d’engagement

Depuis plus de dix ans, le nom de Josée Arsenault est associé à la Fondation IUCPQ. Première femme à présider le conseil d’administration de l’organisation, la mission poursuivie par l’Institut universitaire de cardiologie et de pneumologie de Québec l’interpelle personnellement. Opérée à cœur ouvert, elle a elle-même été patiente à l’IUCPQ, où elle a constaté la qualité des soins qui y étaient offerts.
« J’avais une condition congénitale qui a fait en sorte qu’on a dû me remplacer une artère et une valve pulmonaire, raconte Josée Arsenault. J’ai alors réalisé à quel point j’avais été bien prise en charge. La directrice générale de la Fondation, à l’époque, était l’une de mes amies, et c’est elle qui m’a convaincue de joindre le conseil d’administration. À ce moment-là, je siégeais au conseil du Palais Montcalm. J’ai donc fait le saut de la culture à la santé. »
Propulser la fondation à un autre niveau
Celle qui cumulera en mai trois années à la présidence du conseil d’administration de la Fondation IUCPQ en mai — et qui occupe également un siège au conseil d’administration d’établissement de l’Institut — s’est donné le mandat de « propulser l’IUCPQ à un autre niveau », de « prendre ce lieu d’innovation et de faire une différence ». Elle désirait ardemment apporter quelque chose de nouveau. Josée Arsenault l’admet spontanément : ce qui l’allume, ce sont les défis. En fait, elle y carbure.
« Quand je suis entrée au conseil d’administration de la Fondation, expose-t-elle, j’ai tenté de voir où je pourrais donner mon temps — car nous sommes tous des bénévoles —, et j’ai finalement accepté la présidence du comité de la grande soirée de la campagne de financement annuelle. Au cours des dernières années, celle-ci est passée d’un revenu net de 350 000 $ à 1,25 M$. Pour arriver à ce résultat, il a fallu se réinventer, dépoussiérer la philanthropie. »

Comme une grande famille
Chaque année, la Fondation IUCPQ hausse son objectif, puis élargit son marché dans sa quête de dons auprès de la communauté d’affaires, dans sa recherche de commandites et de partenaires. À ce chapitre, elle se doit de compter sur un conseil d’administration diversifié, qui réunit plusieurs expertises complémentaires parce que chacun a son réseau. L’esprit de collaboration et la culture de transparence qui définissent la Fondation assurent son succès.
« Très ouverte et à l’écoute, notre organisation allie tradition d’excellence et vision d’avenir. La pérennité de la Fondation IUCPQ passe, bien sûr, par une relève qui pourra continuer à incarner l’innovation, l’audace. Notre conseil d’administration cherche constamment de nouvelles ressources, à évoluer, puis à y intégrer des idées novatrices et des passionnés. Quiconque est intéressé par notre fondation est invité à nous contacter… »
Josée Arsenault, présidente du conseil d’administration de la Fondation IUCPQ
Soutenir la Fondation IUCPQ et transformer des vies
Mon épouse et moi serons toujours reconnaissants envers l’Institut universitaire de cardiologie et de pneumologie de Québec (IUCPQ), anciennement connu sous le nom d’Hôpital Laval. Au début des années 1980, mon épouse a eu de graves problèmes d’asthme et elle a été souvent hospitalisée. Grâce aux soins exceptionnels prodigués par l’équipe de pneumologie et aux avancées de la recherche, elle mène aujourd’hui une vie tout à fait normale.
C’est pourquoi je soutiens, depuis longtemps, la Fondation IUCPQ. Je suis bien conscient du rôle joué par l’organisme dans le financement de la recherche, de l’enseignement et de l’acquisition d’équipements de pointe. Et je sais que c’est grâce à cet appui que l’IUCPQ peut demeurer un chef de file mondial en cardiologie, pneumologie et obésité-métabolisme. Faire un don à la Fondation, c’est contribuer concrètement à sauver des vies.
En février 2022, c’était au tour d’un de mes meilleurs amis d’être opéré à cœur ouvert à l’IUCPQ. Heureusement, il s’est rétabli avec succès. Peu après, un autre ami m’a raconté qu’il avait lui aussi subi une importante chirurgie cardiaque malgré une excellente condition physique. Apprendre que sa maladie était d’origine génétique m’a profondément fait réfléchir. Il faut dire que, de mon côté, les maladies cardiovasculaires sont malheureusement bien présentes dans ma famille. Mon père est décédé à 63 ans d’un arrêt cardiaque, et mon frère à 56 ans. Je savais donc que mes risques d’être touché par une telle condition étaient élevés.
L’année suivante, j’ai été invité à participer à la soirée Au cœur de vos passions, ce que j’ai accepté avec plaisir en reconnaissance des soins reçus par mon épouse et par soutien envers mes amis récemment traités. Ce fut une magnifique soirée !
Jamais je n’aurais pu imaginer qu’un an plus tard, ce serait à mon tour de me retrouver sur la table d’opération. À l’été 2024, à la suite d’examens approfondis à l’IUCPQ, j’ai appris que je devais sans tarder subir un double pontage. J’éprouvais depuis quelque temps un essoufflement inhabituel, même lors de mes longueurs à la piscine. L’intervention s’est déroulée avec succès le 1er août 2024. Évidemment, ce fut un grand choc pour moi et mon entourage. Mais c’est à ce moment que j’ai véritablement pris conscience de l’expertise unique des équipes de l’IUCPQ.
En mai 2025, c’est avec fierté que j’ai accepté de collaborer à la soirée Au cœur de vos passions à titre de conseiller en vins. Fort de mes 50 ans d’expérience en sommellerie, c’était pour moi tout naturel d’offrir mes services à une cause aussi significative. Savoir que les fonds recueillis soutiennent des projets prioritaires de l’IUCPQ me touche profondément.
Et mon histoire avec l’IUCPQ n’est pas terminée. Depuis mon opération, j’ai la chance d’être suivi par l’équipe du Pavillon de prévention des maladies cardiaques (PPMC), qui a joué un rôle déterminant dans ma remise en forme. Le 7 septembre 2025, à peine un an après ma chirurgie, j’ai participé pour la première fois au Cyclo-Défi Fondation IUCPQ, en complétant un parcours de 50 km à vélo, un accomplissement dont je suis très fier ! Mon épouse m’accompagne désormais dans mes entraînements au PPMC et, ensemble, nous gardons la forme et savourons chaque moment.
L’été prochain, nous célébrerons notre 50e anniversaire de mariage, et nous savons que c’est en grande partie grâce à l’IUCPQ et à sa Fondation. Merci du fond du cœur, notre reconnaissance est infinie !
Un bouquet de fraîcheur pour la santé de demain
Il est des soirées qui marquent les esprits, des instants suspendus où l’humain se rassemble autour de ce qui compte vraiment. Dans la douceur d’un soir de mai, alors que la nature s’éveille pleinement, un bouquet de fraîcheur devient plus qu’un simple assemblage de fleurs : il incarne un élan collectif, une volonté partagée de faire éclore un avenir plus sain.
Chaque fleur offerte ce soir-là est un geste de philanthropie, une promesse faite à la vie. Derrière ce bouquet vibrant de couleurs et de parfums, c’est toute une communauté qui s’engage à investir dans la santé, à soutenir une Fondation dont la mission est aussi ambitieuse qu’essentielle : créer la médecine de demain, maintenant.
La santé, comme un jardin, se cultive avec soin, patience et vision. Chaque don devient une graine d’espoir, semée pour soutenir la recherche, améliorer les soins et encourager l’innovation. Et lorsque près de 1000 personnes se réunissent autour de cette cause, c’est tout un territoire qui vibre au rythme de la solidarité.
Ce grand moment de philanthropie, prévu le 29 mai prochain, s’annonce comme un rendez-vous unique. À la veille des Fêtes et de l’hiver, alors que l’année s’apprête à tourner une nouvelle page, la Fondation invite chacun à inscrire cette date à son calendrier. Ce sera une soirée à l’image de son Institut : innovante, rassembleuse, tournée vers l’avenir.

sa kinésiologue
© Jacques Fortin, L’Antidote Médias



